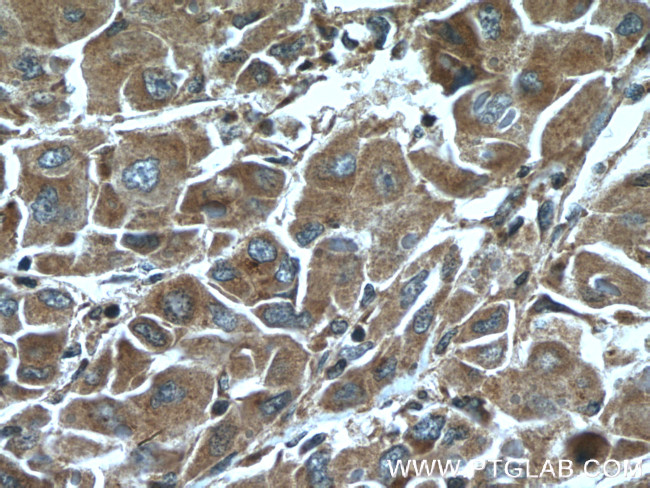
ELAC1 Antibody in Immunohistochemistry (Paraffin) (IHC (P))

Search
Proteintech
ELAC1 Polyclonal Antibody
{{$productOrderCtrl.translations['antibody.pdp.commerceCard.promotion.promotions']}}
{{$productOrderCtrl.translations['antibody.pdp.commerceCard.promotion.viewpromo']}}
{{$productOrderCtrl.translations['antibody.pdp.commerceCard.promotion.promocode']}}: {{promo.promoCode}} {{promo.promoTitle}} {{promo.promoDescription}}. {{$productOrderCtrl.translations['antibody.pdp.commerceCard.promotion.learnmore']}}
产品信息
26639-1-AP
种属反应
宿主/亚型
分类
类型
抗原
偶联物
形式
浓度
规格
纯化类型
保存液
内含物
保存条件
运输条件
产品详细信息
Immunogen sequence: MSMDVTFLG TGAAYPSPTR GASAVVLRCE GECWLFDCGE GTQTQLMKSQ LKAGRITKIF ITHLHGDHFF GLPGLLCTIS LQSGSMVSKQ PIEIYGPVGL RDFIWRTMEL SHTELVFHYV VHELVPTADQ CPAEELKEFA HVNRADSPPK EEQGRTILLD SEENSYLLFD DEQFVVKAFR LFHRIPSFGF SVVEKKRPGK LNAQKLKDLG VPPGPAYGKL KNGISVVLEN GVTISPQDVL KKPIVGRKIC ILGDCSGVVG DGGVKLCFEA DL (1-271 aa encoded by BC014624)
靶标信息
Zinc phosphodiesterase, which displays some tRNA 3'-processing endonuclease activity. Probably involved in tRNA maturation, by removing a 3'-trailer from precursor tRNA.
仅用于科研。不用于诊断过程。未经明确授权不得转售。
篇参考文献 (0)
生物信息学
蛋白别名: D29; Deleted in Ma29; elaC homolog 1; ElaC homolog protein 1; Ribonuclease Z 1; RNase Z 1; RNaseZ(S); similar to Escherichia coli elaC and Homo sapiens HPC2/ELAC2; tRNA 3 endonuclease 1; tRNA 3' processing endoribonuclease; tRNA Z (short form); tRNase Z 1; tRNase ZS; unnamed protein product; Zinc phosphodiesterase ELAC protein 1
基因别名: 2610018O07Rik; 8430417G19Rik; D29; ELAC1
UniProt ID: (Human) Q9H777, (Mouse) Q8VEB6
Entrez Gene ID: (Human) 55520, (Mouse) 114615